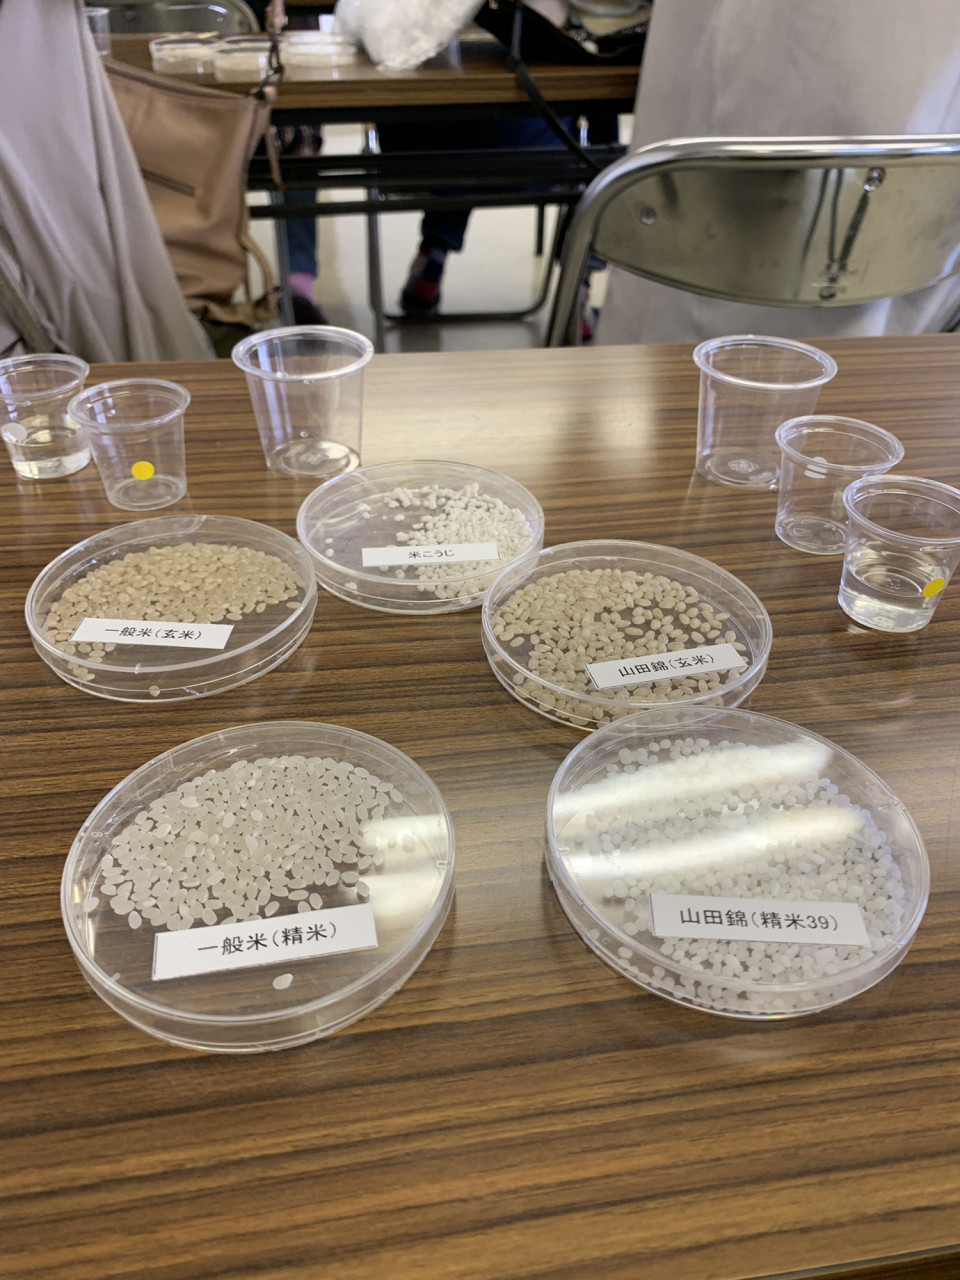

昨年、9年間 子ども3人ともお世話になった幼稚園が卒園のため、何かかできないかと思って、末っ子の卒園パーティー委員をさせて頂きました。
募ったメンバーで、ケータリングをとろうか?とか お弁当でいいかな? 風船を飾ろうか? スターバックスのポットサービスをとろうか?なんて楽しくワクワク計画していました。
しかし 金額はいくらがいいかな?となって途端に分からなくなり。。
皆さんは意見はバラバラなので、
安いほうがいい?
パーティーだし贅沢に?(贅沢といっても5000円以上は絶対ないレベル)
お土産はいるのかいらないのか??etc...
皆さんの意見が見えないまま進めていくと
え?3000円くらいじゃない?
4000円くらいじゃない?
5000円以下ならお任せだよ! etc
いろいろな意見が耳に入ってきて 決めたことが全部最初からやり直しになったりと 色々とあったので急遽探したアプリでした。
簡単操作で、無料アプリ
卒園生保護者の皆さんにアプリを使ってアンケートにお答えしていただきました。
そしてあらかじめ 「多数決で決まった意見に沿ってパーティを進めますね」とお伝えしていたので
・値段設定 ・お土産の有無 ・歌や踊りの了承など サクサクと統計を取り、1番表の多かったところを採用。
その後の 予約ゆ買い物、色々な作業がとてもスムーズになりました。
話はそれてしまいました。
皆様に頂いたアンケート結果、
ちょっとアンケートが長かったから 最後までたどり着かなかった方 申し訳ございません!
cocokitchenお料理レッスンのご希望は
1位がおもてなし料理
2位が普段のお料理でした。
イタリアン、発酵食、薬膳 そのほかでエスニックや諸々。
お料理の内容のリクエストも しっかりと読ませていただきました。
・ご主人がよく釣りをされるので おさかな料理ご希望の方
・お野菜中心がご希望の方
・グルテンフリーや糖質少なめ ダイエットにも良さそうなレシピ
・イタリアンで簡単なもの
・薬膳をもっと習いたいです
・キッズレッスンの「魯肉飯」をご希望の方
簡単スイーツ シフォンケーキ や、
毎年年末に作る「鯖すし」をリクエストにくださった方もいらっしゃいました
以前からローストビーフのリクエストも承っております。
リクエストの中に・グルテンフリーご希望や、簡単時短メニューを今までのレッスンの中からお願いしますというリクエスト
色々頂けてありがたく読ませていただきました。
順番に簡単で 美味しくて 体が喜ぶようなメニューを考えてしていきたいなと改めて 励みになりました。
心から感謝です。
週末には予約の取りにくい状況や、改善しないといけない点がたくさんあったので伺えて良かったです。
楽しいことを教えてやる気が出る花空間に出来たらなと思っています。
興味あり情報に
・ホストファミリーの暮らし
・ダイエット
・おもてなし
・子育ての話 と書いて伺っだ結果
一番ご希望が多かったのは
『段取りと時間の使い方』
でした。
私の時間の使い方・・・
どうしているかな・・・??
改めて 振り返る機会となりました。
最近は 24時間の女性専用ジムができて、(しかも かなり近所に)
7、8月5700円という キャッチーなフレーズにまんまと入会しました。
朝起きて 夫を送って 子供が起きるまでにパジャマで(スエットのような)スッピンのまま自転車で行って Netflixを観ながら (えっと テラスハウスとか テラスハウスとか 動画 、動画 みるもの沢山、 )
柔軟体操をしながら LINEの返信をしたり
いらない写真を消したりして そのあとシャワーをしてお化粧をして 家に8時過ぎに帰宅しています。
朝ドラまでに。
え? 何時に起きるかって? 朝はいつも弱くて 今日は0650
もっと早く起きて落ち着いてきて欲しい夫の希望
無視し続けてしまっています(-。-;
マッハで 忍者のように朝食と 冷蔵庫の中の物をスライドしてお弁当を作り渡して、
今日は夫が出るとほぼ同時に ジムに向けて家を出てほんの束の間のジムタイム(動画タイム)です
タイトなのでドライヤーしながらも 必死で動画を観ています 笑
一人になれる場所って好きです。
夏休み、めちゃくちゃ賑やかでずっと人の物を片付けているので
朝のひと時が 愛しの時間です 笑
他も色々思い出したら 書いていこうと思います
アンケートのご報告は 書きたいことがいっぱいありました
心優しく、 嬉しい言葉もたくさん 嬉しくて小躍り、でも貴重なご意見にも身の引き締まる思いでした。
とっても感謝です
ありがとうございました。
少しづつですが改善したりしながら、cocokitchenがよりよい場所にできたらと思います
]]>





 HATCHi 金沢-THE SHARE HOTELS-【公式】|HATCHi KANAZAWA(ハッチカナザワ)】
HATCHi 金沢-THE SHARE HOTELS-【公式】|HATCHi KANAZAWA(ハッチカナザワ)】


















 ”美腸スタイル 強い心とカラダを作る” 発酵食のエトセトラ
”美腸スタイル 強い心とカラダを作る” 発酵食のエトセトラ


 秋からだ想いの薬膳ご飯 秋の養生 日本四季薬膳レッスン cocokitchen 日本四季大学監修
秋からだ想いの薬膳ご飯 秋の養生 日本四季薬膳レッスン cocokitchen 日本四季大学監修









 atsuco cocokitchen ココキッチン (@atsucococo) • Instagram photos and videos
atsuco cocokitchen ココキッチン (@atsucococo) • Instagram photos and videos


 料理教室 cocokitchen ココキッチン イタリア家庭料理・四季薬膳・発酵食・天然酵母パン
料理教室 cocokitchen ココキッチン イタリア家庭料理・四季薬膳・発酵食・天然酵母パン
 cocokitchen ココキッチン (@cocokitchen125) | Twitter
cocokitchen ココキッチン (@cocokitchen125) | Twitter





 9月 夏の疲れを癒そうイタリアン レモンたっぷりイタリアンcocokitchen
9月 夏の疲れを癒そうイタリアン レモンたっぷりイタリアンcocokitchen

















 《募集》夏のcocokitchen キッズレッスン
《募集》夏のcocokitchen キッズレッスン